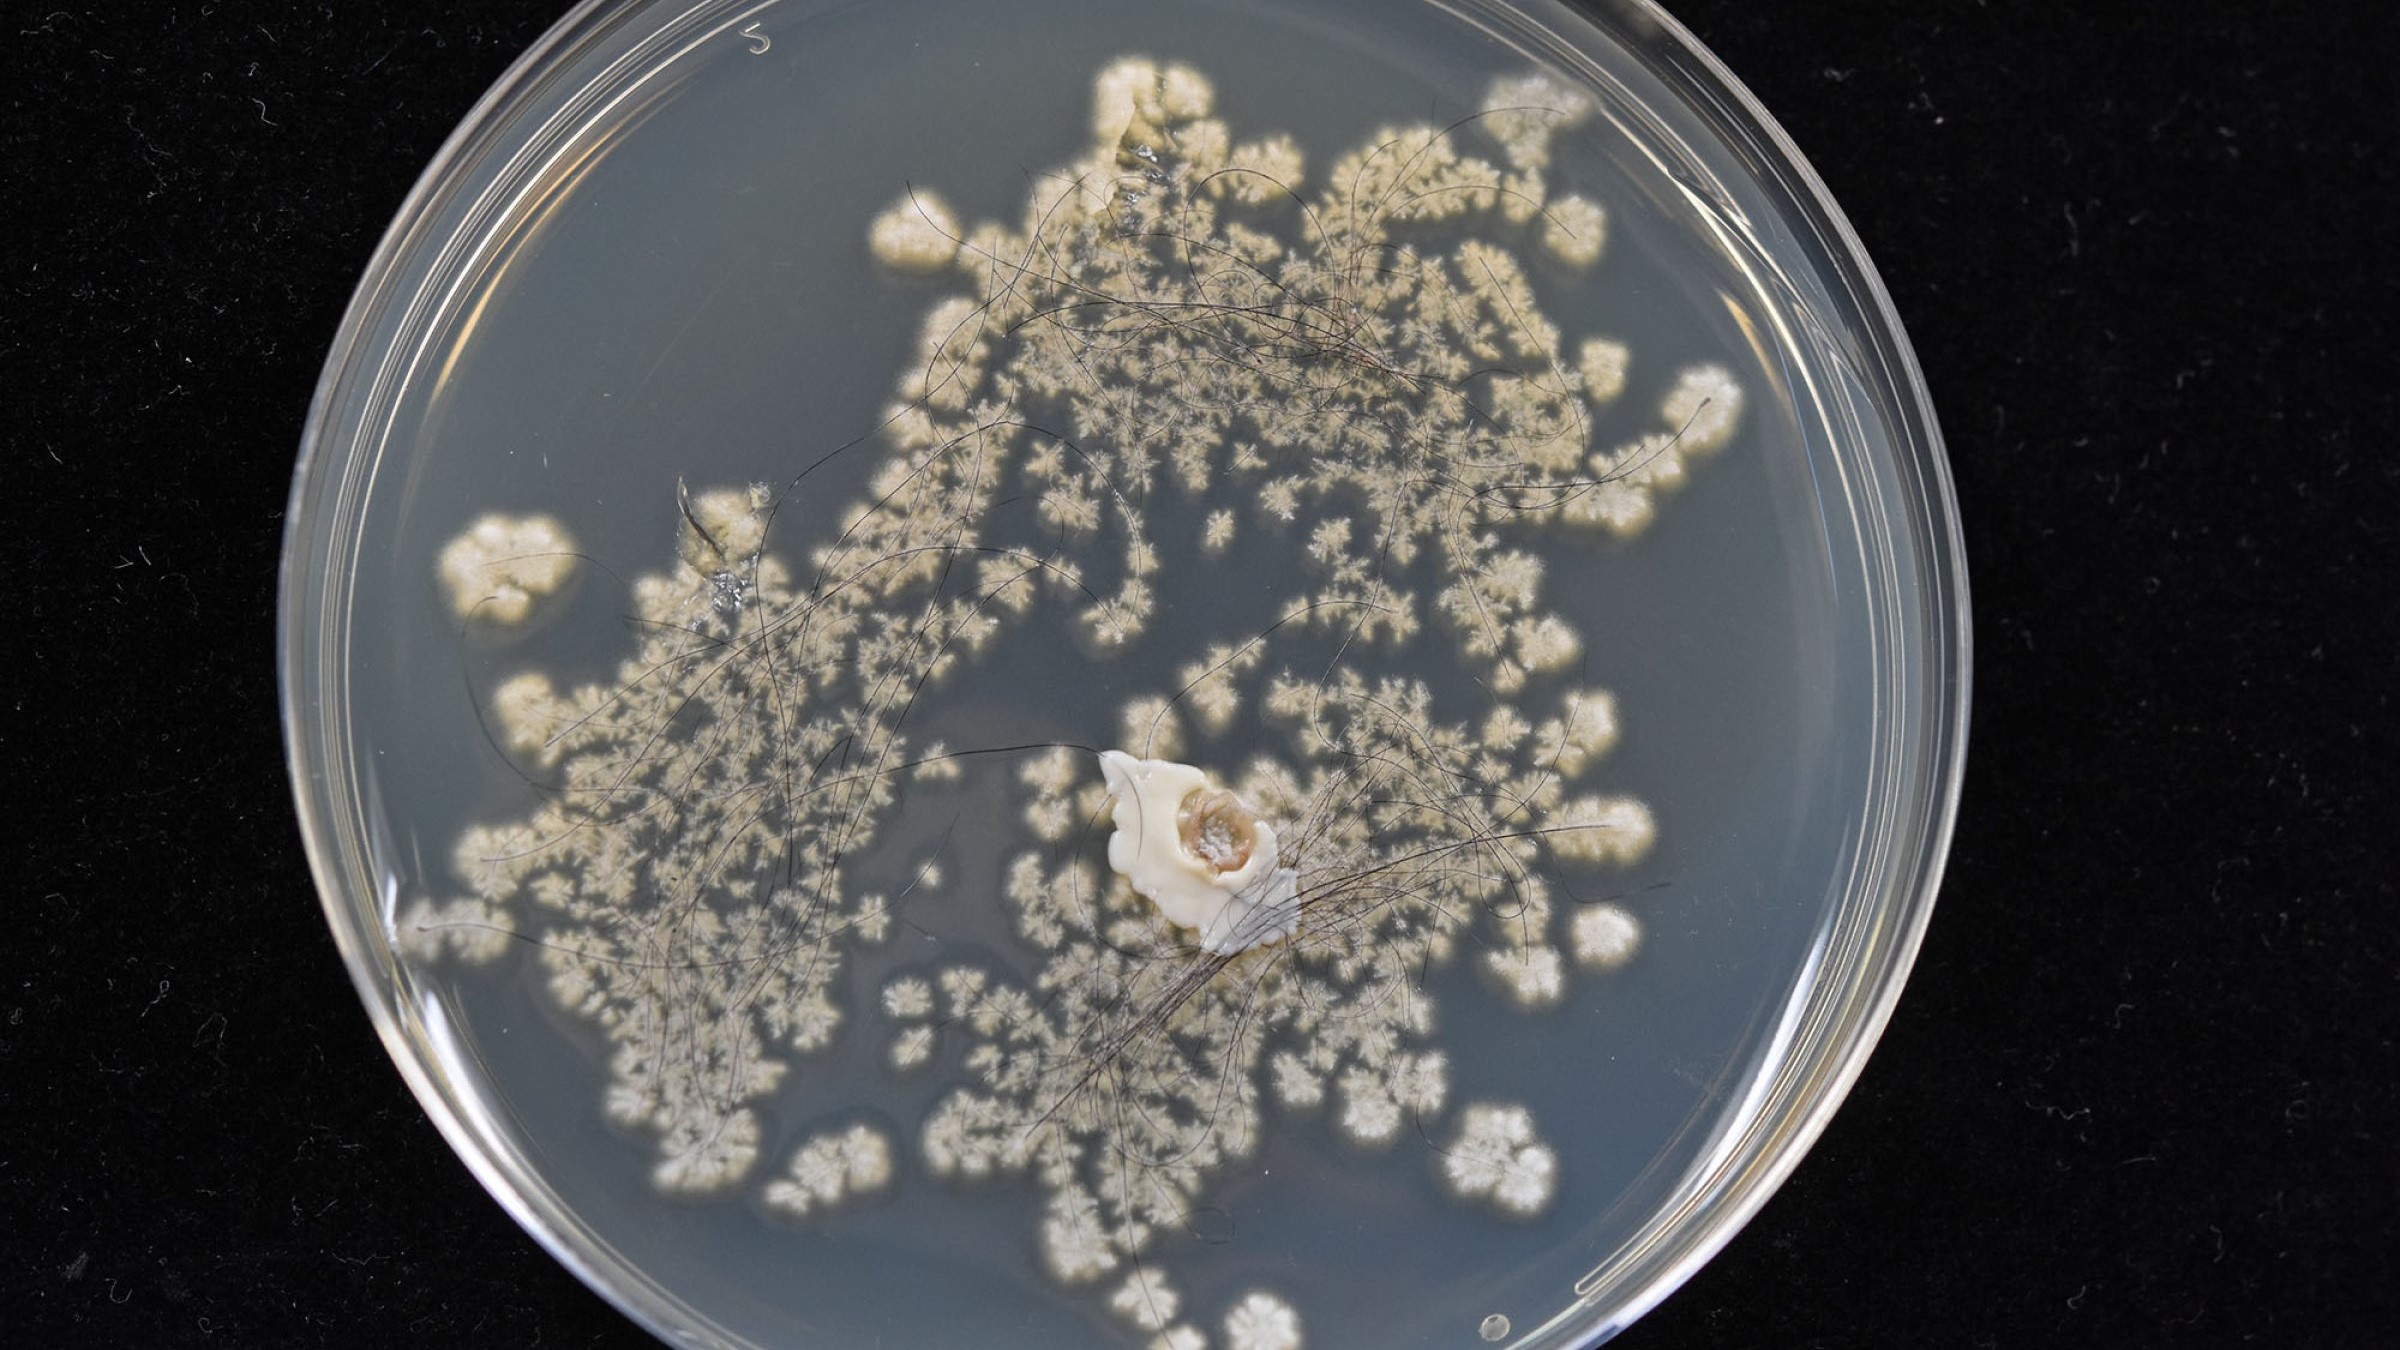

For å redusere slik smitterisiko, er det viktig med en velfungerende smittesluse og at besøkende ikke slurver med bruken av den. Utstyr som ikke må være med inn i fjøset, settes igjen i smitteslusa.
Overtrekksfrakk bør vaskes mellom hver gang den har vært brukt. Rein kjeledress legges fram til veterinær/semintekniker. Besøkende bør dekke til håret og vaske hendene godt etter besøket.